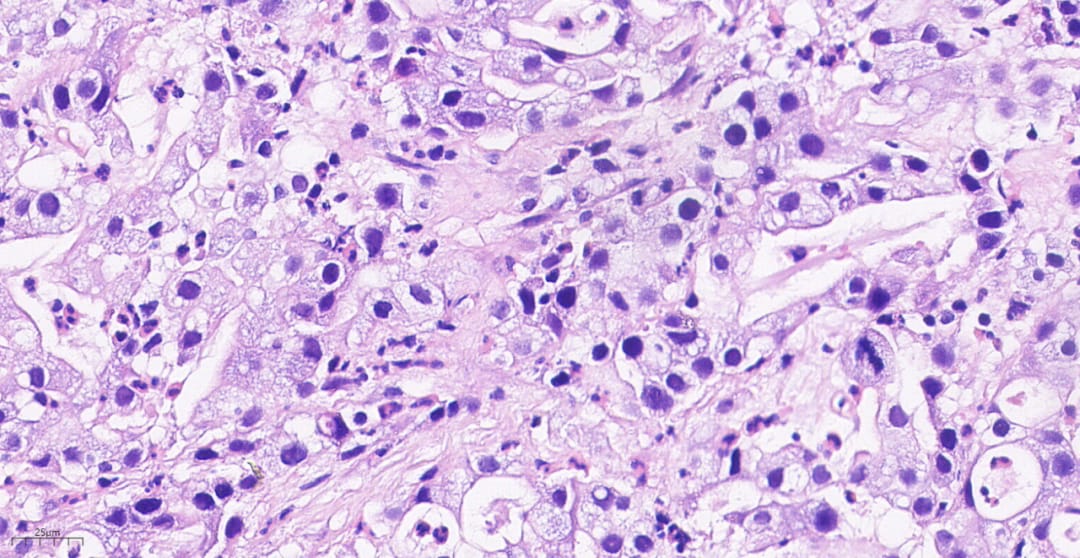
图片
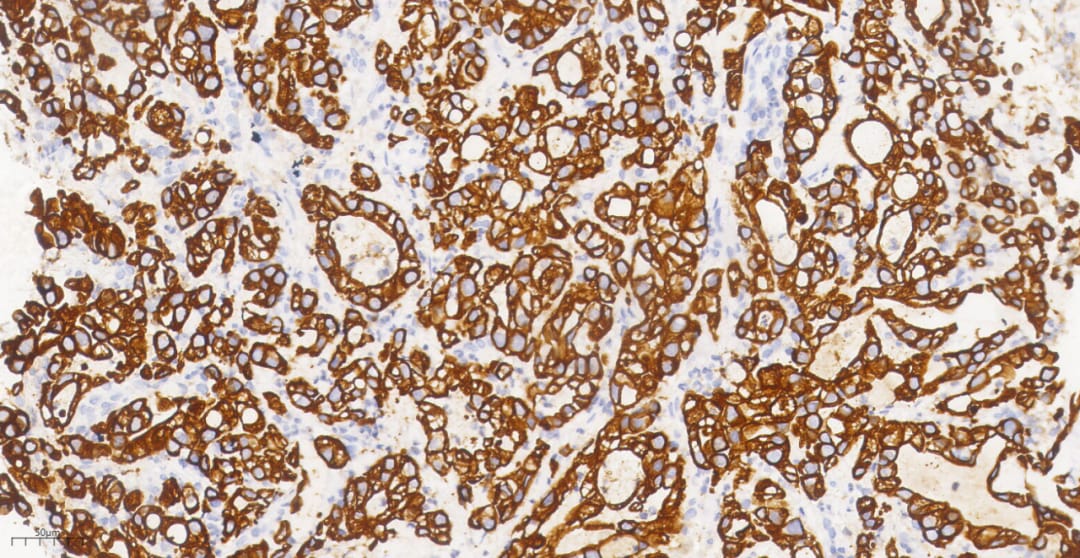
图片
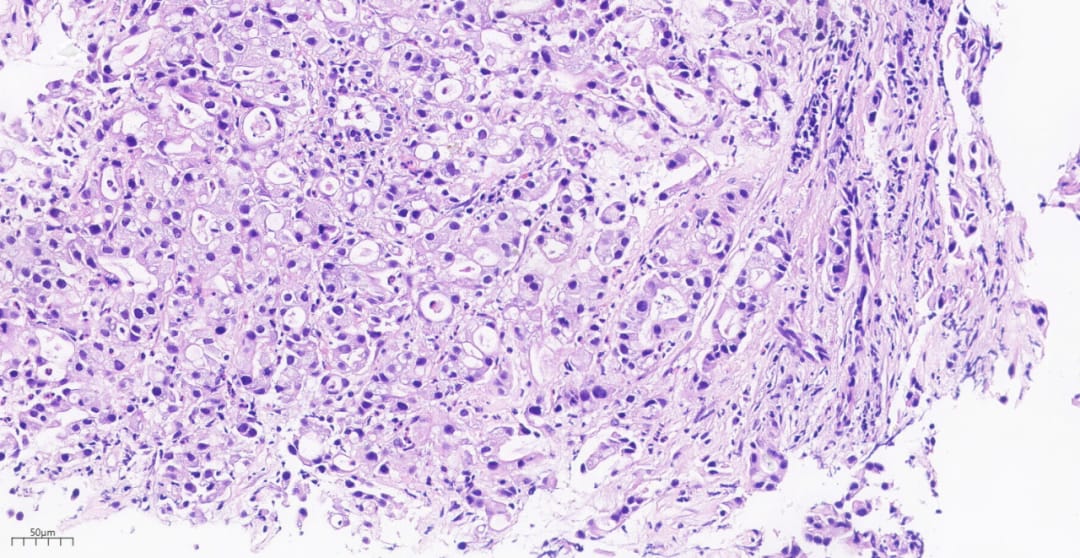
图片

引言:一例真实病例背后的罕见肺癌
当谈及肺癌,人们往往会想到与吸烟相关的常见类型。然而,在肺癌的庞大家族中,存在着一些罕见且极具挑战性的亚型。SMARCA4缺失性肺腺癌就是其中之一。这是一种恶性程度高、进展迅速的肿瘤,对患者的治疗构成了巨大挑战。本文将通过一例真实的临床病例,深入浅出地为您解析这一罕见疾病,帮助您全面了解其诊断、治疗及预后情况。
故事的主人公是一位73岁的男性患者,他有着长达50余年的吸烟史。近一个多月来,他饱受胸骨和右肩部疼痛的困扰,最终选择入院检查。这一检查,揭开了一种罕见肺癌的神秘面纱。
从症状到诊断:SMARCA4缺失性肺腺癌的发现之旅
1. 初步检查:影像学发现异常
入院后,医生为患者安排了详细的胸部CT扫描。结果显示,其左肺上叶出现了团块状的异常高密度影,部分支气管被堵塞,且有不均匀的强化表现。影像学专家初步判断,这很可能是一种肿瘤性病变。此外,CT还发现颈部椎体可能存在转移灶,这预示着病情的复杂性。


图1 胸部CT影像揭示左肺上叶的肿瘤性病变
2. 锁定真凶:病理活检与免疫组化
为了明确病变的性质,医生对患者进行了组织病理活检。在显微镜下,病理医生观察到肿瘤细胞形态异常,排列混乱,呈现出低分化腺癌的特征。这些细胞体积较大,细胞核异型明显,显示出高度的恶性潜能。

图2 显微镜下的肿瘤组织呈弥漫片状分布

图3 肿瘤细胞排列紧密

图4 肿瘤细胞排列成复杂的腺体形态

图5 部分肿瘤细胞排列成腺样结构

图6 高倍镜下可见明显的细胞异型性
然而,要最终确诊,还需要进行一项关键的检测——免疫组化。这项技术就像是给细胞“染色”,通过观察特定蛋白质的表达情况来判断肿瘤的类型。结果显示,该患者的肿瘤细胞中,一种名为BRG1的蛋白质完全缺失(阴性表达)。BRG1蛋白是由SMARCA4基因编码的,它的缺失是诊断SMARCA4缺失性肿瘤的关键证据。

图7 免疫组化显示肿瘤细胞CK7阳性
图8 关键证据:肿瘤细胞BRG1表达缺失
综合所有检查结果,最终的病理诊断为:(左肺上叶开口)低分化腺癌,符合SMARCA4缺失性腺癌。这个诊断揭示了患者所患疾病的罕见性和侵袭性。
深入了解:什么是SMARCA4缺失性非小细胞肺癌?
SMARCA4是一个重要的抑癌基因,它编码的BRG1蛋白在调节细胞生长、分裂和修复DNA损伤中扮演着“守护者”的角色。当SMARCA4基因发生突变或缺失,这位“守护者”便会失职,导致细胞不受控制地增殖,最终形成肿瘤。
这类肿瘤在2021年被世界卫生组织(WHO)正式命名,属于非小细胞肺癌(NSCLC)的一个特殊亚型,全称为SMARCA4缺失性非小细胞肺癌(SMARCA4-dNSCLC)。它具有以下几个显著的临床病理特征:
- 高发人群: 更常见于有长期吸烟史的中老年男性,男性患者数量远超女性。
- 高侵袭性: 肿瘤生长迅速,体积通常较大,容易出现内部坏死,并倾向于早期发生远处转移。
- 分子特征: 除了SMARCA4缺失外,常常伴随有TP53、KRAS、STK11等其他关键基因的突变,这使得治疗变得更加复杂。
- 病理形态: 在显微镜下,肿瘤细胞黏附性差,常呈片状或岛状分布,显示出高度的异型性。
对于被诊断为罕见癌症的患者,获取全面的疾病信息和前沿治疗方案至关重要。MedFind的AI问诊服务可以帮助您快速梳理复杂的医疗信息,为您匹配个性化的治疗建议和临床试验机会。
诊断难点与鉴别诊断
由于SMARCA4-dNSCLC的形态多变,在诊断过程中很容易与其他类型的肺癌混淆,特别是那些分化较差的肿瘤。因此,病理医生需要将其与以下几种疾病进行仔细鉴别:
- 经典型肺腺癌: 一些SMARCA4缺失的肺腺癌在形态上可能与普通肺腺癌相似,因此建议对实体型为主的肺腺癌常规进行BRG1免疫组化检测,以避免漏诊。
- SMARCA4缺失的未分化肿瘤(SMARCA4-DUT): 这是另一种与SMARCA4缺失相关的胸部肿瘤,但其分化程度更低,几乎没有上皮分化的特征。
- 转移性肿瘤: 卵巢癌、子宫肉瘤等其他部位的肿瘤也可能发生SMARCA4缺失。在诊断肺原发肿瘤前,必须排除来自其他器官转移的可能性。
准确的诊断是制定有效治疗方案的第一步。因此,对于疑似病例,进行详细的病理学检查和包括BRG1在内的免疫组化检测是必不可少的。
治疗挑战与未来希望
目前,SMARCA4-dNSCLC的治疗仍然是一个巨大的挑战。由于其恶性程度高,大多数患者在确诊时已属晚期,失去了手术机会。
- 传统化疗: 部分研究表明,这类肿瘤细胞可能对铂类化疗药物更为敏感,但临床实践中患者从化疗中获得的益处仍然有限,总体预后不佳。
- 免疫治疗: PD-1/PD-L1抑制剂等免疫检查点抑制剂在肺癌治疗中取得了革命性进展,但其在SMARCA4-dNSCLC患者中的疗效仍在探索中,现有数据尚不一致,需要更多研究来证实。
- 靶向治疗: 尽管SMARCA4本身难以直接靶向,但科学家们正在积极研究利用其“合成致死”的弱点。例如,研究发现,SMARCA4缺失的肿瘤可能对KDM6或CDK4/6抑制剂等药物敏感。这些新兴疗法为患者带来了新的希望,但大多仍处于临床研究阶段。
面对这种棘手的疾病,积极参与临床试验、探索新的治疗方案可能是改善预后的重要途径。如果您或您的家人需要获取前沿的治疗药物,但面临购药困难,MedFind致力于为全球癌症患者提供安全、便捷的药品代购服务,确保您能及时获得治疗希望。
结语
SMARCA4缺失性肺腺癌作为一种罕见且凶险的肺癌亚型,对临床诊断和治疗提出了严峻的考验。通过对这一个案的深入剖析,我们不仅了解了其独特的临床病理特征,也看到了医学界在攻克这一难题上所面临的挑战与机遇。随着基因检测技术的普及和对肿瘤分子机制研究的深入,我们有理由相信,未来将有更多创新的治疗策略涌现,为这类患者带来更长的生存期和更好的生活质量。更多关于肺癌的最新资讯和诊疗指南,请持续关注MedFind抗癌资讯中心。
